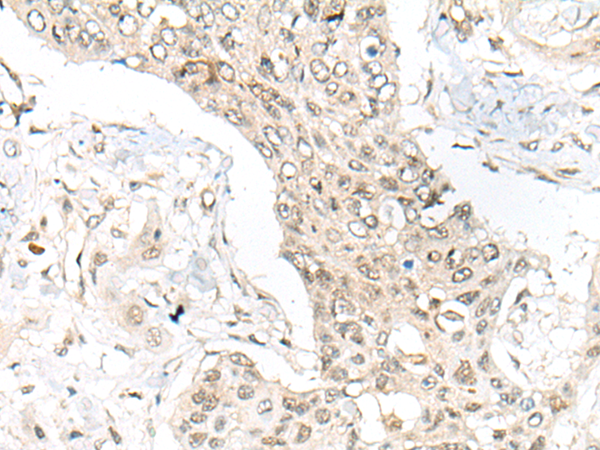

-
分类: 科研抗体货号: P12915别名: UGT1; HUGT1; UGCGL1应用: WB,IHC反应种属: Human
-
分类: 科研抗体货号: P12914别名: HER4; ALS19; p180erbB4应用: IHC反应种属: Human, Mouse, Rat
-
分类: 科研抗体货号: P12928别名: MDS; BOPS应用: IHC反应种属: Human, Mouse
-
分类: 科研抗体货号: P12912别名: DCC1应用: WB,IHC反应种属: Human, Mouse
-
分类: 科研抗体货号: P12944别名: TUBB; TUBB2; CDCBM5应用: WB,IHC反应种属: Human, Mouse, Rat
-
分类: 科研抗体货号: P12927别名: WDR50; CGI-48应用: WB,IHC反应种属: Human, Mouse
-
分类: 科研抗体货号: P12911别名: UK; UMPK; TSA903应用: IHC反应种属: Human, Mouse, Rat
-
分类: 科研抗体货号: P12943别名: BCNP1; FAM129C应用: IHC反应种属: Human
-
分类: 科研抗体货号: P12926别名:应用: IHC反应种属: Human
-
分类: 科研抗体货号: P12910别名: UBXD3应用: IHC反应种属: Human

鄂公网安备42018502007531号
鄂公网安备42018502007531号

